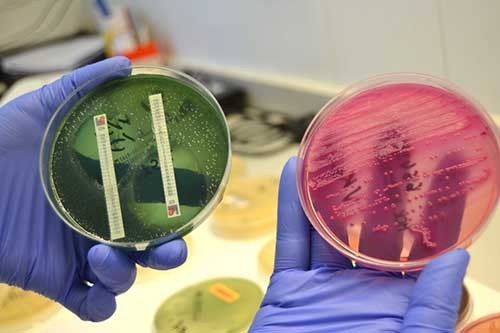

Este día se celebra para concienciar de su importancia y aumentar el conocimiento que la población tiene sobre la sepsis, con el objetivo de disminuir la cifra de fallecidos.

La sepsis es una reacción anómala del organismo ante una infección provocada por bacterias u otros microorganismos que conduce a una disfunción de los órganos vitales. Requiere de un tratamiento precoz e intensivo para mejorar su pronóstico. El 14% de las atenciones realizadas en urgencias son debidas a un proceso infeccioso. De entre ellas, el 6% de los pacientes presentan sepsis. Su incidencia es de 3 por cada 1.000 habitantes, aumentando con la edad hasta alcanzar el 13,1 por 1.000 habitantes en la población mayor de 65 años. Su incidencia es mayor que otros procesos frecuentes con el infarto o el cáncer.
En los países más desarrollados, la sepsis aumenta en una proporción anual de entre 8-13%.
Los signos y síntomas de alarma que deben hacer buscar ayuda médica son la presencia, en el contexto de una infección, de alteración del nivel de consciencia, dificultad respiratoria, aumento de la frecuencia cardiaca o respiratoria, náuseas o vómitos o hipotensión.
La población más susceptible a sufrir sepsis son los ancianos, diabéticos, pacientes con enfermedades crónicas, pacientes con cáncer, o inmunodeprimidos. El incremento de esta población, el uso más habitual de dispositivos implantables o el aumento de infecciones por microorganimos resistentes a los antibióticos, hacen que la incidencia de la sepsis se incrementa año a año, así como el número absoluto de muertos.